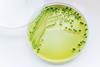
shutterstock_468354635

All Bioassays, potency and characterisation articles
-
News
AI driving automated microbiological testing market growth to 2033
Regulatory pressures and demand for trained operators is expected to hinder growth of the rapid microbiological testing market into the next decade, research suggests.
-
 News
NewsNanomaterial research potential “game-changer” for drug delivery
The throughput achieved by the researchers exceeded that of other reported methods by orders of magnitude, supporting the advancement of precision nanomaterials.
-
 News
NewsAlternative methods for mycobacterial testing in biological products
Considering the limited available information on implementing mycobacterial testing for quality control of biologicals, researchers have highlighted a suitable potential alternative detection method.
-
 News
NewsNovel PAT tool could improve pharmaceutical QC
The at-line PAT method utilised machine-vision and was able to predict API content of tablets containing amlodipine and valsartan with low relative errors.
-
 News
NewsHow will automation shape deviation management in continuous bioprocessing?
A paper has proposed how advanced manufacturing process technologies such as integrated continuous bioprocesses (ICB) could impact the future of deviation detection and control.
-
 News
NewsBiosensing technique promising for whole-genome detection
The bacterial detection method is robust and highly sensitive over a wide concentration range and does not require DNA amplification, research suggests.
-
News
NewsWill new therapeutic agent replace antibodies for bacterial detection?
Aptamers offer a “cutting-edge approach” for identifying gram-negative bacterial pathogens, a paper suggests.
-
 News
NewsAchieving optimal advanced process control in bioproduction
Model Predictive Control (MPC) “stands out as a beacon of advanced control” in continuous manufacturing, through its ability to enhance efficacy within bioproduction, research suggests.
-
 News
NewsRegulatory revision essential for bioprocess IIoT adoption
A limited number of Industrial Internet of Things (IIoT) applications exist in the bioprocessing industry and remain to be challenged in manufacturing operations, research has highlighted.
-
 News
NewsFully instrumented 3D printed small-scale bioreactor developed
To support upstream bioprocess development, a study has demonstrated real-time monitoring of the growth phase in a 3D printed, single-use bioreactor.
-
Whitepaper
Application note: Highly efficient method development for analysis of oligonucleotides
Thorough quality control of nucleic acid drugs is important to ensure their safety and efficacy. In this application, an automated computer-aided workflow was used for highly efficient method development.
-
 News
NewsPioneering PAT to improve gene therapy AAV manufacture
The CGT Catapult and two other collaborators have agreed to work together and use advanced process analytical technologies (PAT) to improve the process and efficiency of gene therapy AAV manufacturing.
-
 News
NewsNew mass spec technique identified for electron ionisation direct analysis
A paper has depicted extractive-liquid sampling electron ionisation-mass spectrometry (E-LEI-MS) as a new real-time MS technique for direct analysis.
-
 News
NewsNovel PAT system could enable adaptive process control
A paper has demonstrated a novel refractometry-based process analytical technology (PAT) system has potential for enabling adaptive process control in CGT manufacturing.
-
 News
NewsMicrofluidic device detects bacteria concentration from small sample volumes
A novel ultrasonic nanosieve enabled concentration of bacteria into a 1µL highly concentrated solution suitable for plate counting and PCR, according to research.



